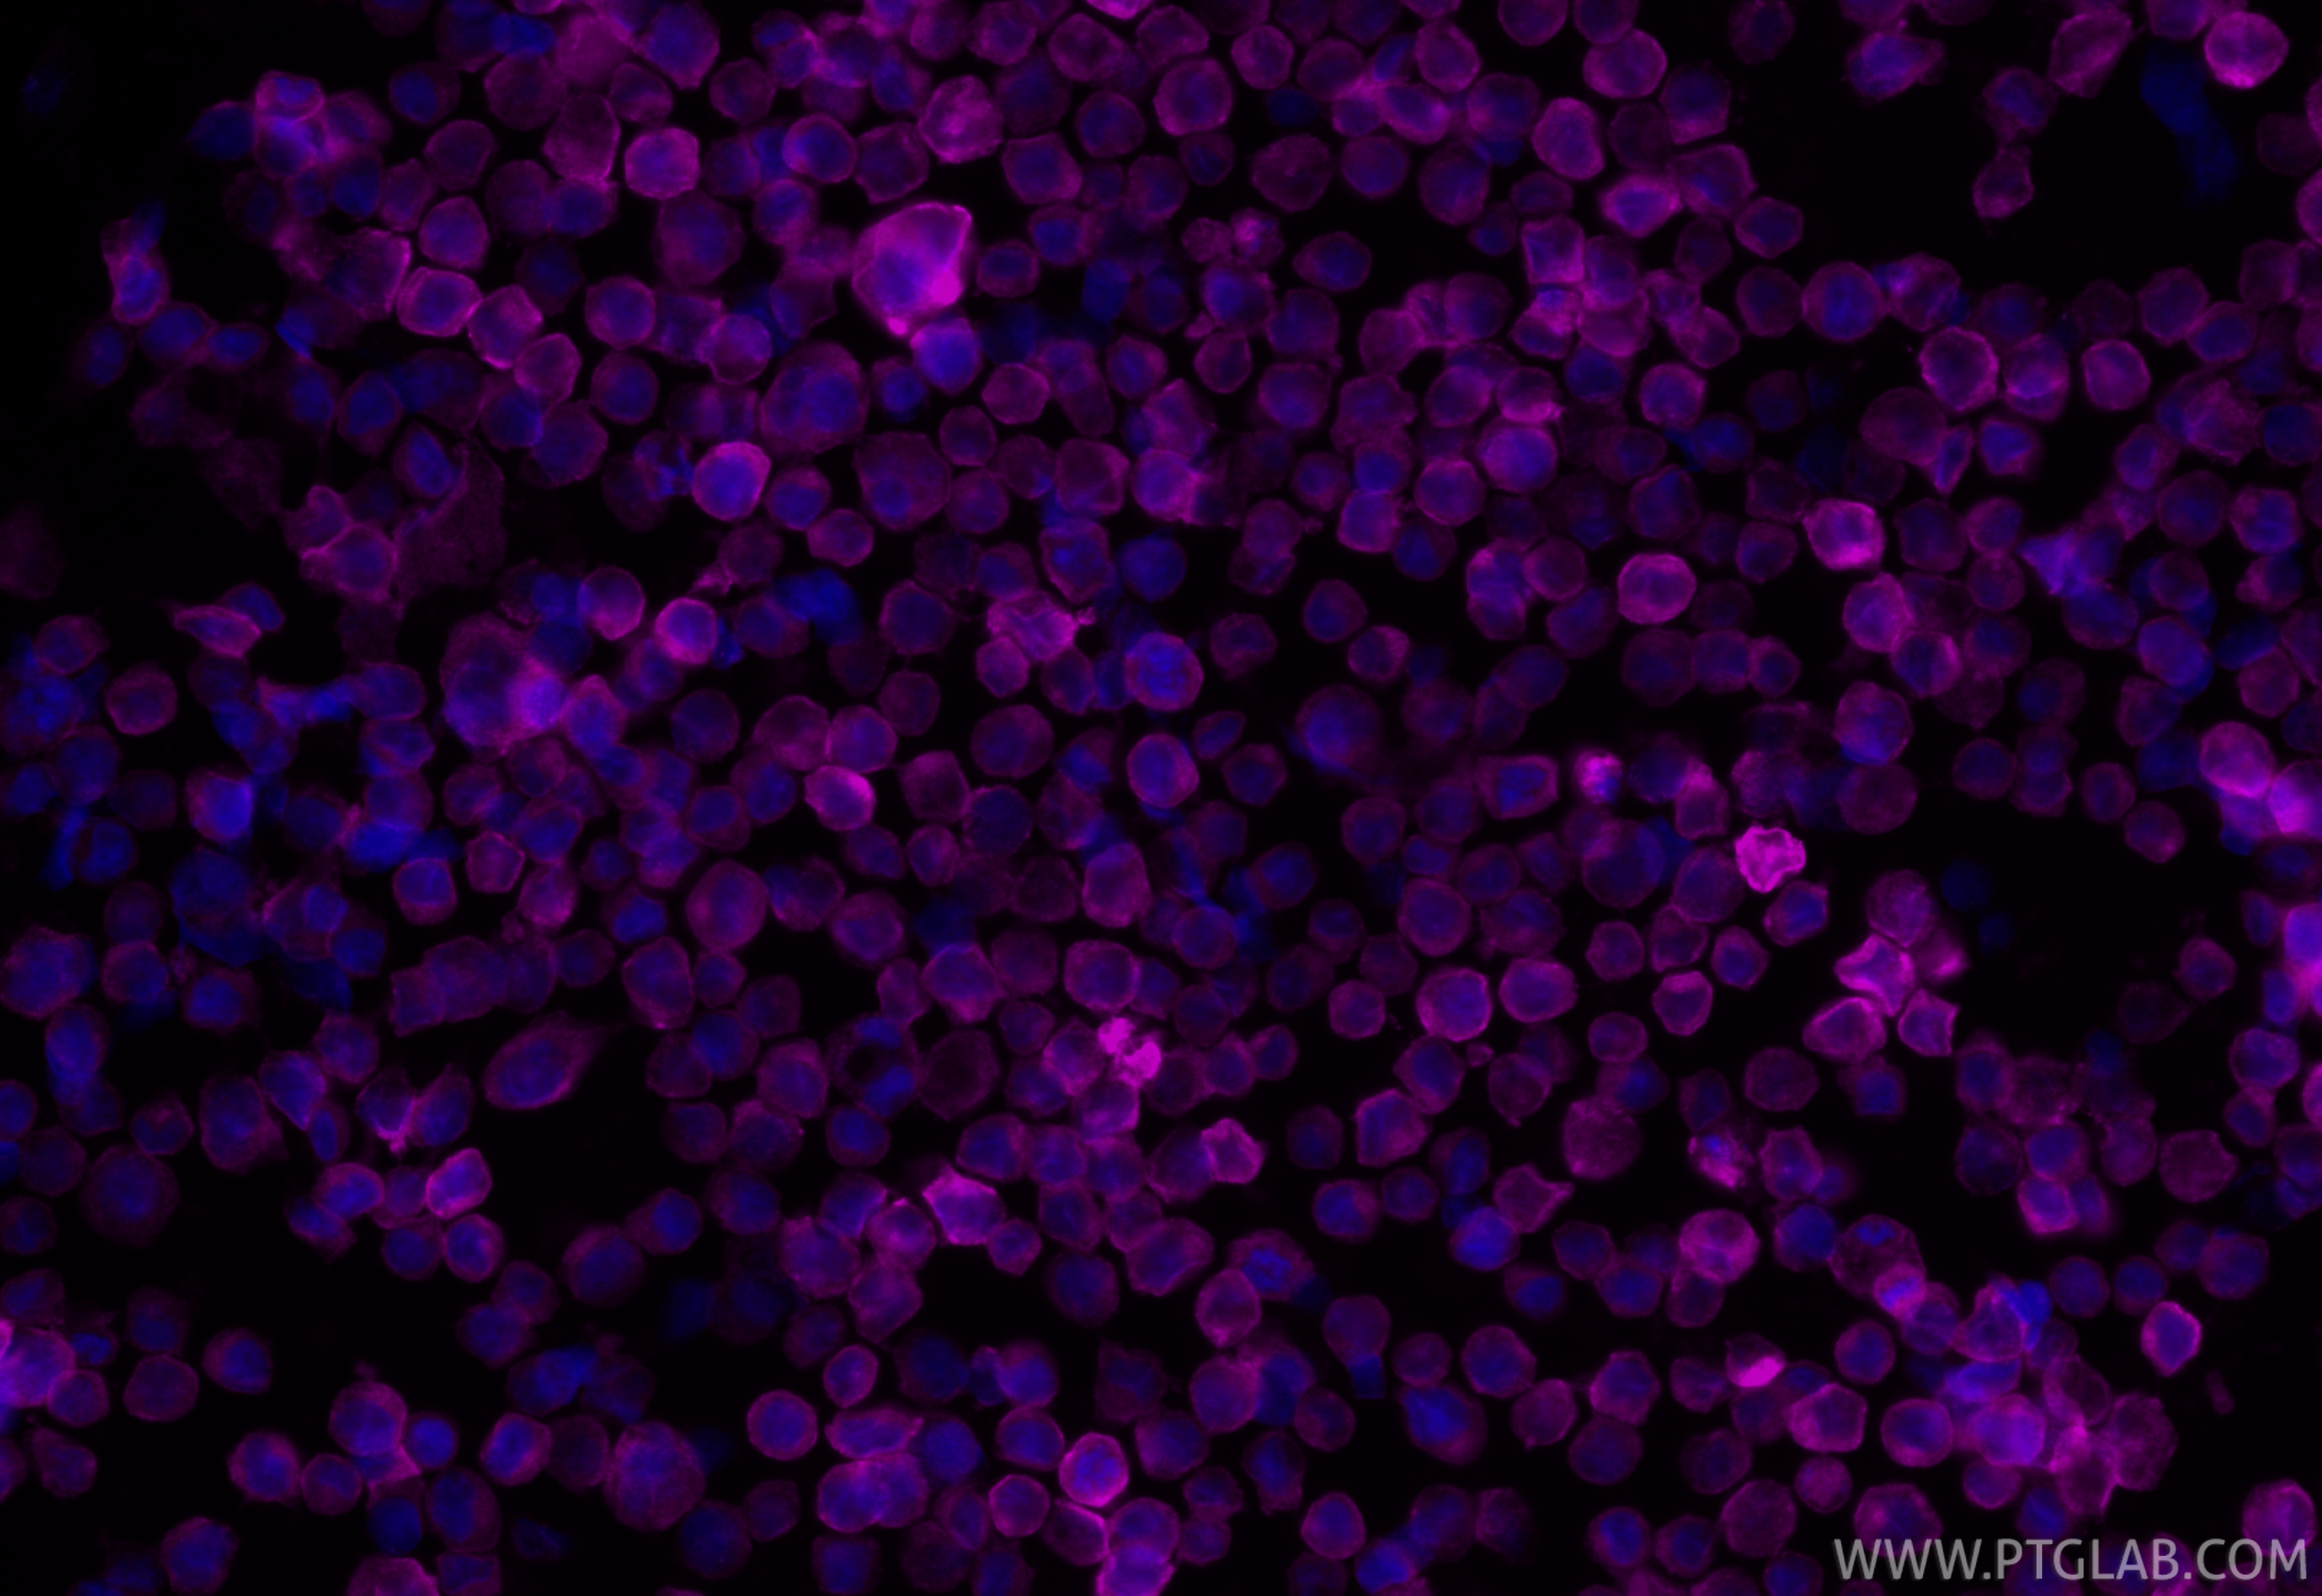
Immunofluorescent analysis of (4% PFA) fixed Raji cells using CoraLite® Plus 647 CD80 antibody (CL647-83198-4, Clone: 242913H3 ) at dilution of 1:200. IF Staining of Raji using CL647-83198-4

验证数据展示
经过测试的应用
| Positive IF/ICC detected in | Raji cells |
推荐稀释比
| 应用 | 推荐稀释比 |
|---|---|
| Immunofluorescence (IF)/ICC | IF/ICC : 1:50-1:500 |
| It is recommended that this reagent should be titrated in each testing system to obtain optimal results. | |
| Sample-dependent, Check data in validation data gallery. | |
产品信息
CL647-83198-4 targets CD80 in IF/ICC applications and shows reactivity with human samples.
| 经测试应用 | IF/ICC Application Description |
| 经测试反应性 | human |
| 免疫原 |
CatNo: Eg3505 Product name: Recombinant Human CD80/B7-1 protein (rFc Tag) Source: mammalian cells-derived, pHZ-KIsec-C-rFc Tag: C-rFc Domain: 35-242 aa of NM_005191 Sequence: VIHVTKEVKEVATLSCGHNVSVEELAQTRIYWQKEKKMVLTMMSGDMNIWPEYKNRTIFDITNNLSIVILALRPSDEGTYECVVLKYEKDAFKREHLAEVTLSVKADFPTPSISDFEIPTSNIRRIICSTSGGFPEPHLSWLENGEELNAINTTVSQDPETELYAVSSKLDFNMTTNHSFMCLIKYGHLRVNQTFNWNTTKQEHFPDN 种属同源性预测 |
| 宿主/亚型 | Rabbit / IgG |
| 抗体类别 | Recombinant |
| 产品类型 | Antibody |
| 全称 | CD80 molecule |
| 别名 | 242913H3, Activation B7 1 antigen, Activation B7-1 antigen, B7, B7 1 |
| 计算分子量 | 33 kDa |
| GenBank蛋白编号 | NM_005191 |
| 基因名称 | CD80 |
| Gene ID (NCBI) | 941 |
| 偶联类型 | CoraLite® Plus 647 Fluorescent Dye |
| 最大激发/发射波长 | 654 nm / 674 nm |
| 形式 | Liquid |
| 纯化方式 | Protein A purification |
| UNIPROT ID | P33681 |
| 储存缓冲液 | PBS with 50% glycerol, 0.05% Proclin300, 0.5% BSA, pH 7.3. |
| 储存条件 | Store at -20°C. Avoid exposure to light. Stable for one year after shipment. Aliquoting is unnecessary for -20oC storage. |
背景介绍
CD80 (also known as B7-1) is a type I membrane protein that is a member of the immunoglobulin superfamily, with an extracellular immunoglobulin constant-like domain and a variable-like domain required for receptor binding. It is expressed on antigen-presenting cells (APCs), including B cells, dendritic cells, monocytes, and macrophages. CD80 is the receptor for the proteins CD28 and CTLA-4 found on the surface of T-cells. It is involved in the costimulatory signal essential for T-lymphocyte activation. T-cell proliferation and cytokine production is induced by the binding of CD28, binding to CTLA-4 has opposite effects and inhibits T-cell activation. CD80 also acts as a cellular attachment receptor for adenovirus subgroup B. (PMID: 7545666; 12015893; 16920215)
实验方案
| Product Specific Protocols | |
|---|---|
| IF protocol for CL Plus 647 CD80 antibody CL647-83198-4 | Download protocol |
| Standard Protocols | |
|---|---|
| Click here to view our Standard Protocols |